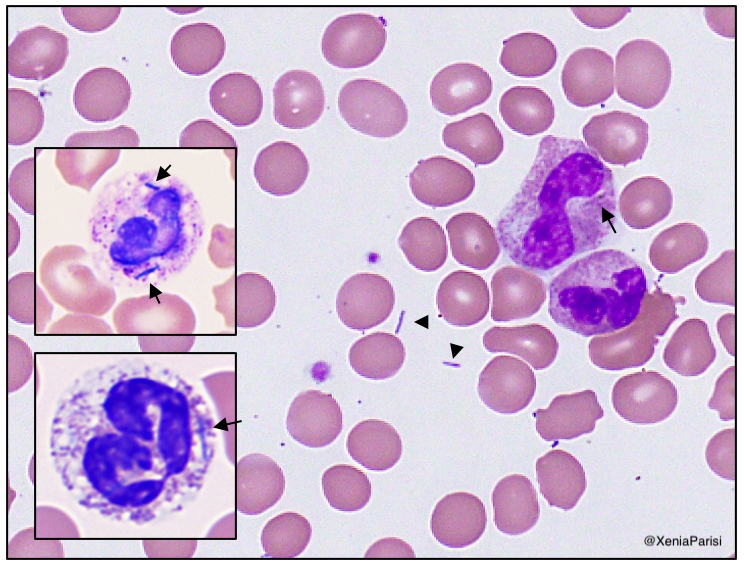
Purpura fulminans w/ infectious etiology favored. Blood Cx pending & pt started on broad-spectrum abx. ID requesting prelim on peripheral smear. Slides stained with Wright-Giemsa and (inlay) dilute Giemsa.Thoughts?

73M Hx TTP s/p splenectomy 10yr prior, otherwise healthy p/w worsening malaise, fevers, chills x24hr. PE wnl. Labs sig for mildly elevated lactate. Pt held for fluids & obs.
In 6hrs, thrombocytopenic, coagulopathic, rising lactate with pH 7.1 & rapidly developing retiform rash.
In 6hrs, thrombocytopenic, coagulopathic, rising lactate with pH 7.1 & rapidly developing retiform rash.
Purpura fulminans w/ infectious etiology favored. Blood Cx pending & pt started on broad-spectrum abx. ID requesting prelim on peripheral smear. Slides stained with Wright-Giemsa and (inlay) dilute Giemsa.
Thoughts?
Thoughts?
Blood Cx positive at 24hrs.
Gram stain showing thin, spindled, GNRs.
Plated, green on chocolate and pitting agar, negative on MacConkey at 48hrs.
Gliding-motility, indole & oxidase-negative.
Diagnosis? A very interesting day on call @BIDMCpath!
Gram stain showing thin, spindled, GNRs.
Plated, green on chocolate and pitting agar, negative on MacConkey at 48hrs.
Gliding-motility, indole & oxidase-negative.
Diagnosis? A very interesting day on call @BIDMCpath!
MALDI-TOF & 16S rRNA confirmed Capnocytophaga canimorsus, an oral commensal in dogs & cats.
So, sepsis eventuating in purpura fulminans in asplenic pts is frequently caused by capsule-bearing bacteria, esp Neisseria/Streptococcus, but remember to include C. canimorsus in the Ddx!
So, sepsis eventuating in purpura fulminans in asplenic pts is frequently caused by capsule-bearing bacteria, esp Neisseria/Streptococcus, but remember to include C. canimorsus in the Ddx!

 Read on Twitter
Read on Twitter